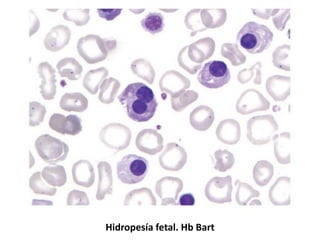
Hidropesía fetal. Hb Bart
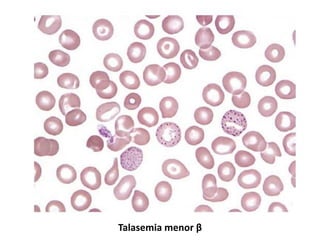
Talasemia menor β
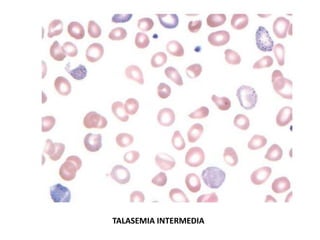
TALASEMIA INTERMEDIA

Este documento describe las talasemias, un grupo de trastornos hereditarios que causan una producción insuficiente de las cadenas de hemoglobina. Explica los diferentes tipos como la talasemia alfa, beta y H, así como sus genotipos y manifestaciones clínicas que van desde anemia leve hasta dependencia de transfusiones. También cubre las anormalidades eritrocitarias presentes y los métodos de diagnóstico.